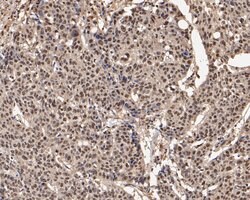
Invitrogen UBA3 Monoclonal Antibody (1B5-2-3) 100 &mu;L; Unconjugated:Antibodies,
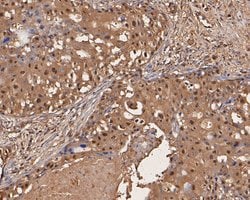
Invitrogen UBA3 Monoclonal Antibody (1B5-2-3) 100 &mu;L; Unconjugated:Antibodies,

missing translation for 'onlineSavingsMsg'
Learn More
Learn More
Invitrogen™ UBA3 Monoclonal Antibody (1B5-2-3)


Mouse Monoclonal Antibody
Brand: Invitrogen™ MA536104
This item is not returnable.
View return policy
Description
UBA3 Monoclonal Antibody for Western Blot, ICC/IF, IHC (P), Flow
The modification of proteins with ubiquitin is an important cellular mechanism for targeting abnormal or short-lived proteins for degradation. Ubiquitination involves at least three classes of enzymes: ubiquitin-activating enzymes, or E1s, ubiquitin-conjugating enzymes, or E2s, and ubiquitin-protein ligases, or E3s. This gene encodes a member of the E1 ubiquitin-activating enzyme family. The encoded enzyme associates with AppBp1, an amyloid beta precursor protein binding protein, to form a heterodimer, and then the enzyme complex activates NEDD8, a ubiquitin-like protein, which regulates cell division, signaling and embryogenesis. Multiple alternatively spliced transcript variants encoding distinct isoforms have been found for this gene.
Specifications
| UBA3 | |
| Monoclonal | |
| 2 mg/mL | |
| PBS with 0.2% BSA, 50% glycerol and 0.05% sodium azide; pH 7.4 | |
| Q8C878, Q8TBC4 | |
| Uba3 | |
| Recombinant protein within Human UBA3 aa 220-424. | |
| 100 μL | |
| Primary | |
| Human, Mouse | |
| Antibody | |
| IgG2a |
| Flow Cytometry, Immunohistochemistry (Paraffin), Western Blot, Immunocytochemistry | |
| 1B5-2-3 | |
| Unconjugated | |
| Uba3 | |
| A830034N06Rik; AI256736; AI848246; AW546539; DKFZp566J164; hUBA3; MGC22384; NAE2; NEDD8-activating enzyme E1 catalytic subuni-like protein; NEDD8-activating enzyme E1 catalytic subunit; NEDD8-activating enzyme E1 subunit 2; NEDD8-activating enzyme E1C; Nedd8-activating enzyme hUba3; Uba3; UBA3, ubiquitin-activating enzyme E1 homolog; UBE1C; ubiquitin like modifier activating enzyme 3; ubiquitin-activating enzyme 3; Ubiquitin-activating enzyme E1C; ubiquitin-activating enzyme E1C (homologous to yeast UBA3); ubiquitin-activating enzyme E1C (UBA3 homolog, yeast); ubiquitin-like modifier activating enzyme 3; ubiquitin-like modifier-activating enzyme 3; Unknown (protein for MGC:140052); wu:fb75e04; wu:fc37b11; zgc:55528 | |
| Mouse | |
| Protein A | |
| RUO | |
| 22200, 9039 | |
| Store at 4°C short term. For long term storage, store at -20°C, avoiding freeze/thaw cycles. | |
| Liquid |
Product Content Correction
Your input is important to us. Please complete this form to provide feedback related to the content on this product.
Product Title
Spot an opportunity for improvement?Share a Content Correction